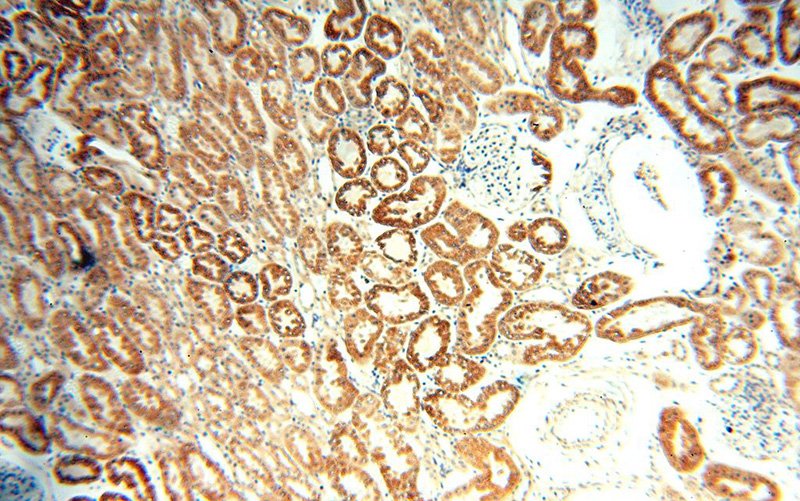
Immunohistochemical of paraffin-embedded human kidney using Catalog No:107851(AIF antibody) at dilution of 1:100 (under 10x lens)
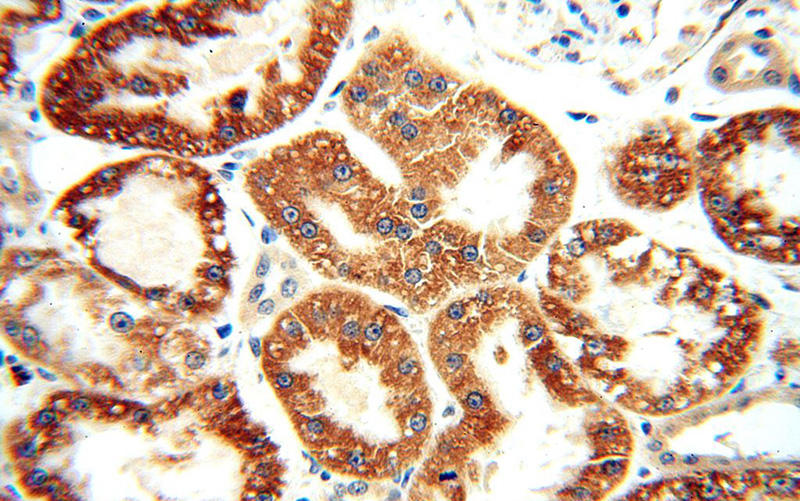
Immunohistochemical of paraffin-embedded human kidney using Catalog No:107851(AIF antibody) at dilution of 1:100 (under 40x lens)

-
Product Name
AIF antibody
- Documents
-
Description
AIF Rabbit Polyclonal antibody. Positive IHC detected in human kidney tissue. Positive IF detected in HepG2 cells. Positive IP detected in HeLa cells. Positive WB detected in Jurkat cells, A549 cells, HeLa cells, rat kidney tissue. Observed molecular weight by Western-blot: 67kd
-
Tested applications
ELISA, IHC, WB, IP, IF
-
Species reactivity
Human,Mouse,Rat; other species not tested.
-
Alternative names
AIF antibody; AIFM1 antibody; PDCD8 antibody
-
Isotype
Rabbit IgG
-
Preparation
This antibody was obtained by immunization of AIF recombinant protein (Accession Number: NM_145812). Purification method: Antigen affinity purified.
-
Clonality
Polyclonal
-
Formulation
PBS with 0.02% sodium azide and 50% glycerol pH 7.3.
-
Storage instructions
Store at -20℃. DO NOT ALIQUOT
-
Applications
Recommended Dilution:
WB: 1:1000-1:10000
IP: 1:1000-1:10000
IHC: 1:20-1:200
IF: 1:10-1:100
-
Validations

Jurkat cells were subjected to SDS PAGE followed by western blot with Catalog No:107851(AIF antibody) at dilution of 1:2000
Immunohistochemical of paraffin-embedded human kidney using Catalog No:107851(AIF antibody) at dilution of 1:100 (under 10x lens)
Immunohistochemical of paraffin-embedded human kidney using Catalog No:107851(AIF antibody) at dilution of 1:100 (under 40x lens)

IP Result of anti-AIF (IP:Catalog No:107851, 3ug; Detection:Catalog No:107851 1:2000) with HeLa cells lysate 1320ug.

Immunofluorescent analysis of HepG2 cells using Catalog No:107851(AIF Antibody) at dilution of 1:25 and Alexa Fluor 488-congugated AffiniPure Goat Anti-Rabbit IgG(H+L)
-
Background
Apoptosis-inducing factor (AIF) is one of the mitochondrial proteins to be released into the cytosol during apoptosis, and it is discovered as the first protein that regulates caspase-independent apoptosis(PMID:20494118). AIF is encoded as a 67 kDa protein that contains a mitochondrial localization signal (MLS) in the N-terminus.It is cleaved from the 62 kDa to the 57 kDa form following ischemic injury and translocated from the mitochondria to the nucleus in a calpain-dependent manner(PMID:19332058).
-
References
- Zheng S, Chang S, Lu J. Characterization of 9-nitrocamptothecin liposomes: anticancer properties and mechanisms on hepatocellular carcinoma in vitro and in vivo. PloS one. 6(6):e21064. 2011.
- Tu JB, Dong Q, Hu XY. Proteomic analysis of mitochondria from infantile hemangioma endothelial cells treated with sodium morrhuate and its liposomal formulation. Journal of biochemical and molecular toxicology. 26(9):374-80. 2012.
- Tu JB, Ma RZ, Dong Q. Induction of apoptosis in infantile hemangioma endothelial cells by propranolol. Experimental and therapeutic medicine. 6(2):574-578. 2013.
- Chen XM, Bai Y, Zhong YJ. Wogonin has multiple anti-cancer effects by regulating c-Myc/SKP2/Fbw7α and HDAC1/HDAC2 pathways and inducing apoptosis in human lung adenocarcinoma cell line A549. PloS one. 8(11):e79201. 2013.
- Nie H, Xue X, Li J. Nitro-oleic acid attenuates OGD/R-triggered apoptosis in renal tubular cells via inhibition of Bax mitochondrial translocation in a PPAR-γ-dependent manner. Cellular physiology and biochemistry : international journal of experimental cellular physiology, biochemistry, and pharmacology. 35(3):1201-18. 2015.
- Liao H, Bao X, Zhu J. O-Alkylated derivatives of quercetin induce apoptosis of MCF-7 cells via a caspase-independent mitochondrial pathway. Chemico-biological interactions. 242:91-8. 2015.
Related Products / Services
Please note: All products are "FOR RESEARCH USE ONLY AND ARE NOT INTENDED FOR DIAGNOSTIC OR THERAPEUTIC USE"
